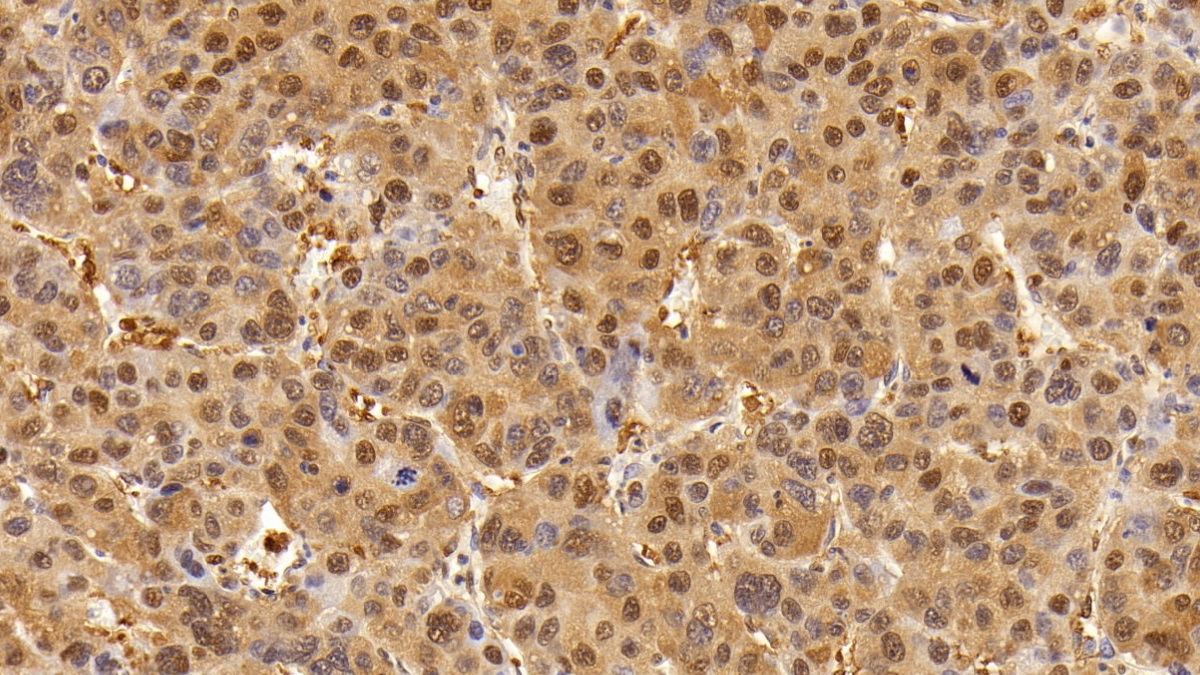

Anti-Glyceraldehyde-3-Phosphate Dehydrogenase (GAPDH) Monoclonal Antibody 

G3PD; GAPD; Peptidyl-cysteine S-nitrosylase GAPDH
Overview
Properties
- Product No.CAB932Mi22
- Organism SpeciesHomo sapiens (Human), Mus musculus (Mouse), Rattus norvegicus (Rat) Same name, Different species.
- ApplicationsWB; IHC; ICC/IF
Research use only - DownloadInstruction Manual
- CategoryEnzyme & KinaseMetabolic pathwayCardiovascular biologyHepatologyNutrition metabolism
- PurificationProtein A + Protein G affinity chromatography
- LabelNone
- Buffer Formulation0.01M PBS, pH7.4, containing 0.05% Proclin-300, 50% glycerol.
- TraitsLiquid, Concentration 1mg/ml
Sign into your account
Share a new citation as an author
Upload your experimental result
Review

Contact us
Please fill in the blank.
Specifity
The antibody is a mouse monoclonal antibody raised against GAPDH. It has been selected for its ability to recognize GAPDH in immunohistochemical staining and western blotting.
Usage
Enzyme-Linked Immune Sorbent Assay:
Immunohistochemistry: 5-20µg/mL;
Immunocytochemistry: 5-20µg/mL;
Optimal working dilutions must be determined by end user.
Storage
Store at 4°C for frequent use. Stored at -20°C in a manual defrost freezer for two year without detectable loss of activity. Avoid repeated freeze-thaw cycles.
Stability
The thermal stability is described by the loss rate. The loss rate was determined by accelerated thermal degradation test, that is, incubate the protein at 37°C for 48h, and no obvious degradation and precipitation were observed. The loss rate is less than 5% within the expiration date under appropriate storage condition.
Organism Species More: Homo sapiens (Human), Mus musculus (Mouse), Rattus norvegicus (Rat), Cavia (Guinea pig ), Hamster (Chinese hamster), Oryctolagus cuniculus (Rabbit), Sus scrofa; Porcine (Pig), Bos taurus; Bovine (Cattle), Capra hircus; Caprine (Goat), Ovis aries; Ovine (Sheep), Equus caballus; Equine (Horse), Chicken (Gallus)Giveaways
Increment services
-
 Antibody Labeling Customized Service
Antibody Labeling Customized Service
-
 Protein A/G Purification Column
Protein A/G Purification Column
-
 Staining Solution for Cells and Tissue
Staining Solution for Cells and Tissue
-
 Positive Control for Antibody
Positive Control for Antibody
-
 Tissue/Sections Customized Service
Tissue/Sections Customized Service
-
 Phosphorylated Antibody Customized Service
Phosphorylated Antibody Customized Service
-
 Western Blot (WB) Experiment Service
Western Blot (WB) Experiment Service
-
 Immunohistochemistry (IHC) Experiment Service
Immunohistochemistry (IHC) Experiment Service
-
 Immunocytochemistry (ICC) Experiment Service
Immunocytochemistry (ICC) Experiment Service
-
 Flow Cytometry (FCM) Experiment Service
Flow Cytometry (FCM) Experiment Service
-
 Immunoprecipitation (IP) Experiment Service
Immunoprecipitation (IP) Experiment Service
-
 Immunofluorescence (IF) Experiment Service
Immunofluorescence (IF) Experiment Service
-
 Buffer
Buffer
-
 DAB Chromogen Kit
DAB Chromogen Kit
-
 SABC Kit
SABC Kit
-
 Long-arm Biotin Labeling Kit
Long-arm Biotin Labeling Kit
-
 Real Time PCR Experimental Service
Real Time PCR Experimental Service
Citations
- Inactivation of the p53–KLF4–CEBPA Axis in Acute Myeloid LeukemiaPubMed: 26408402
- Inactivation of the p53–KLF10–CEBPA Axis in Acute Myeloid LeukemiaPubMed: 26408402
- Dapagliflozin modulates glucagon secretion in an SGLT2-independent manner in murine alpha cells.pubmed:28499695
- Adhesion of Toxoplasma gondii tachyzoite-infected vehicle leukocytes to capillary endothelial cells triggers timely parasite egressionpubmed:28720868
- Biochemical characterization of the PHARC associated serine hydrolase ABHD12 reveals its preference for very long chain lipidsPubmed: 30237167
- Untangling the response of bone tumor cells and bone forming cells to matrix stiffness and adhesion ligand density by means of hydrogelsPubmed: 30343256
- Influence of Magnetite Nanoparticles and Quantum Dots on the Expression of Reference Genes in Peripheral Blood CellsPubmed: 30488202
- Discovery, Optimization and Target Identification of Novel Potent Broad-Spectrum Antiviral InhibitorsPubmed: 30938999
- Methionine enkephalin (MENK) regulates the immune pathogenesis of type 2 diabetes mellitus via the IL-33/ST2 pathwayPubmed: 31078923
- Rationale for a Combination Therapy Consisting of MCL1-and MEK-Inhibitors in Acute Myeloid LeukemiaPubmed: 31718075
- Linc-OIP5 in the breast cancer cells regulates angiogenesis of human umbilical vein endothelial cells through YAP1/Notch/NRP1 signaling circuit at a tumor …Pubmed: 32046779
- Silence of FAM83H-AS1 promotes chemosensitivity of gastric cancer through Wnt/β-catenin signaling pathwayPubmed: 32028241
- Ginger and turmeric lipid-solubles attenuate heated oil-induced oxidative stress in the brain via the upregulation of NRF2 and improve cognitive function in ratsPubmed: 33170419
- Evaluation of the effect of herbal extracts and their bioactive compounds against motion sickness by regulating neurotransmitter levels in vitro and in vivo
- Regulation of hepatic lipid metabolism in CB1-/-and Abcb4-/--HBV surface protein transgenic mice
- BMI1-Inhibitor PTC596 in Combination with MCL1 Inhibitor S63845 or MEK Inhibitor Trametinib in the Treatment of Acute Leukemia. Cancers 2021, 13, 58133540760
- Omega-3 Eicosapentaenoic Acid Reduces Prostate Tumor Vascularity33262291
- Curcumin derivative ST09 modulates the miR-199a-5p/DDR1 axis and regulates proliferation and migration in ovarian cancer cells34837026
- Curcumin alters distinct molecular pathways in breast cancer subtypes revealed by integrated miRNA/mRNA expression analysisPubmed:34981672
- Retinoic acid receptor beta protects striatopallidal medium spiny neurons from mitochondrial dysfunction and neurodegenerationPubmed:35151792
- Arabidopsis GELP7 functions as a plasma membrane-localized acetyl xylan esterase, and its overexpression improves saccharification efficiencyPubmed:35577991